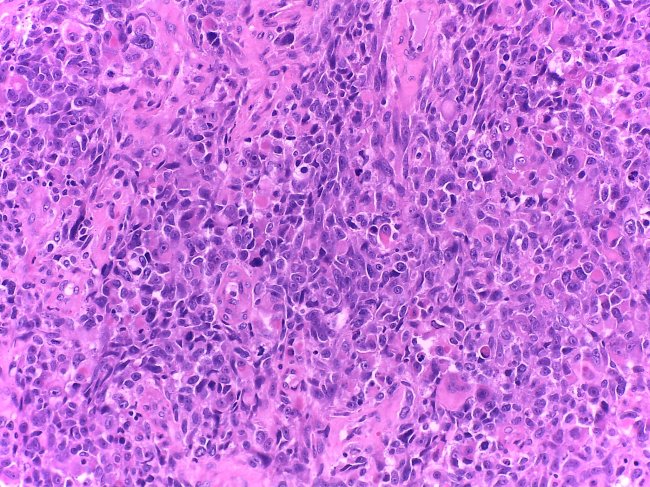

Unidade de Ginecologia Oncológica
A Unidade de Ginecologia Oncológica é a entidade responsável pela organização e convergência de percursos de doentes e protocolos clínicos no diagnóstico e tratamento de cancro do ovário, cólo do útero, endométrio e outras patologias ginecológicas malignas.
Organização Clínica
Na CUF Oncologia, esta unidade tem uma coordenação a sul e outra a norte do país, de forma a uniformizar e transversalizar as melhores práticas na abordagem ao tumores ginecológicos, nos hospitais e clínicas da rede CUF.
É composta por uma equipa multidisciplinar de especialistas na abordagem aos referidos tumores.
Os nossos doentes e os seus cuidadores contam com um acompanhamento de grande proximidade, transmitindo confiança e esperança na recuperação da doença.
Ao seu dispor encontrará enfermeiros dedicados que o acompanham passo a passo para que se sinta sempre seguro e informado e uma equipa de gestores oncológicos, que facilitam todo o processo administrativo.
Coordenação:
Unidade de Ginecologia Oncológica a Sul: José Silva Pereira, Ginecologista, e Mariana Malheiro, Oncologista
Unidade de Ginecologia Oncológica a Norte: Miguel Abreu, Oncologista, e Vanda Patrício, Ginecologista
Faça o seu pedido de contacto para o podermos acompanhar desde o primeiro momento.
Se preferir pode agendar uma consulta através da nossa linha gratuita.
As especialidades mais envolvidas na abordagem aos tumores ginecológicos são:
- Ginecologia Oncológica
- Oncologia Médica
- Anatomia Patológica
- Radioterapia
- Radiologia/Imagiologia
- Medicina Nuclear
- Cirurgia Geral
Os meios de diagnóstico utilizados e protocolados dependem do tipo de cancro.
Cancro do Endométrio
- Ecografia Transvaginal
- Histeroscopia
- Curetagem / Biópsia
Cancro do colo do Útero
- Colposcopia
- CEC
- Biópsia
- Conização
Cancro do Ovário
- Ecografia Pélvica
- TAC
- RMN
- Biopsia guiada
O tratamento é individualizado e depende do tipo de cancro e do estádio em que a doença é diagnosticada.
Cancro do Endométrio
- Cirurgia
- Radioterapia
- Quimioterapia
Cancro do colo do Útero
- Cirurgia
- Quimio-Radioterapia
- Quimioterapia
Cancro do Ovário
- Cirurgia Cito-Redução
- Quimioterapia
Serviços Clínicos de Apoio
- Hospital de Dia
- Internamento
- Bloco Operatório
- Cuidados Intensivos
- Cuidados Paliativos
- Atendimento Permanente
- Linha de Apoio 24 horas
- Nutrição
- Onco-psicologia
- Todas as especialidades
Conheça os fatores de risco e os sintomas deste tipo de cancro ginecológico.

Nas últimas décadas, o número de casos de cancro do colo do útero diagnosticados anualmente tem vindo a diminuir, sobretudo pela sensibilização da importância do rastreio.

Centros
Os Centros CUF encontram-se organizados de forma multidisciplinar e agregadora, proporcionando um acompanhamento completo com base numa organização assente num percurso clínico de um grupo de doenças, órgãos ou especialidades médicas.





